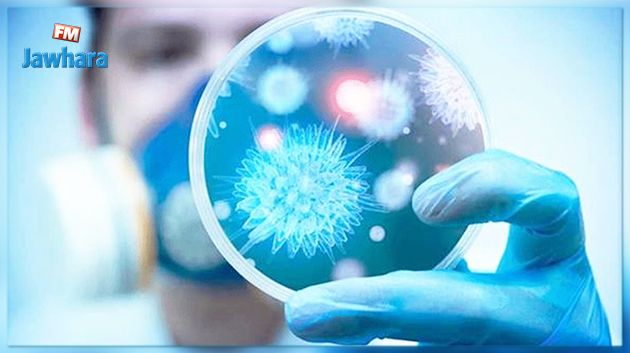

- أخبار
- دولية
- 2021/09/01 09:43
4 نسخ متحوّرة مثيرة للقلق: مراقبة نسخة متحوّرة جديدة من كورونا اسمها "مو"
أعلنت منظمة الصحّة العالمية ليل الثلاثاء-الأربعاء أنّها تراقب نسخة متحوّرة جديدة من فيروس كورونا اسمها "مو" رُصدت للمرة الأولى في كولومبيا في جانفي الماضي.
وقالت المنظمة في نشرتها الوبائية الأسبوعية حول تطوّر الجائحة إنّ النسخة المتحوّرة بي.1.621 بحسب تسميتها العلمية - تمّ تصنيفها في الوقت الراهن "متحوّرة يجب مراقبتها".
وأوضحت أنّ لدى هذه المتحوّرة طفرات يمكن أن تنطوي على خطر "هروب مناعي" (مقاومة للّقاحات)، الأمر الذي يجعل من الضروري إجراء مزيد من الدراسات عليها لفهم خصائصها بشكل أفضل.
تحوّر بمرور الوقت
وجميع الفيروسات، بما في ذلك سارس-كوف-2 المسبّب لمرض كوفيد-19، تتحوّر بمرور الوقت. وإذا كان للغالبية العظمى من الطفرات تأثير ضئيل أو معدوم على خصائص الفيروس، إلا أنّ بعض هذه الطفرات يمكن أن يؤثّر على خصائص الفيروس كأن يزيد على سبيل المثال من سهولة انتشاره أو من مدى شدّة المرض الذي يسبّبه أو من مدى مقاومته للّقاحات أو الأدوية أو أدوات التشخيص أو غيرها من التدابير الاجتماعية والصحّية العامّة. وبسبب ظهور متحوّرات في نهاية 2020 شكّلت خطراً متزايداً على الصحّة العامّة عمدت منظمة الصحة العالمية إلى وضع قائمة بالمتحوّرات التي يجب مراقبتها وتلك المثيرة للقلق، وذلك بهدف أجل إعطاء الأولوية لأنشطة المراقبة والبحث على المستوى العالمي.
وقرّرت منظمة الصحّة العالمية أن تطلق على المتحوّرات التي يجب مراقبتها وتلك المثيرة للقلق أسماء أحرف الأبجدية اليونانية بدلاً من اسم البلد الذي رصدت فيه للمرة الأولى، وذلك منعاً لإلحاق أيّ وصمة بهذا البلد ولتسهيل نطق الأسماء على عامة الناس.
4 نسخ
وفي الوقت الراهن هناك، وفقاً لمنظمة الصحة العالمية، أربع نسخ متحوّرة مثيرة للقلق، بينها المتحورة ألفا التي انتشرت حتى اليوم في 193 دولة والمتحوّرة دلتا التي انتشرت حتى اليوم في 170 دولة، في حين هناك خمس متحوّرات أخرى يجب مراقبتها (بما في ذلك المتحورة "مو").
ورصدت المتحوّرة "مو" للمرة الأولى في كولومبيا في جانفي. ومنذ ذلك الحين تم الإبلاغ عن إصابات بها في عدد من دول أميركا اللاتينية وأوروبا.
وأوضحت منظمة الصحة العالمية أنّه "على الرّغم من أنّ الانتشار العالمي للمتحوّرة مو بين الحالات المتسلسلة قد انخفض ويقلّ حالياً عن 0.1%، إلا أن انتشارها في كولومبيا (39%) والإكوادور (13%) يزيد باضطراد".
وأوضحت أنّ لدى هذه المتحوّرة طفرات يمكن أن تنطوي على خطر "هروب مناعي" (مقاومة للّقاحات)، الأمر الذي يجعل من الضروري إجراء مزيد من الدراسات عليها لفهم خصائصها بشكل أفضل.
تحوّر بمرور الوقت
وجميع الفيروسات، بما في ذلك سارس-كوف-2 المسبّب لمرض كوفيد-19، تتحوّر بمرور الوقت. وإذا كان للغالبية العظمى من الطفرات تأثير ضئيل أو معدوم على خصائص الفيروس، إلا أنّ بعض هذه الطفرات يمكن أن يؤثّر على خصائص الفيروس كأن يزيد على سبيل المثال من سهولة انتشاره أو من مدى شدّة المرض الذي يسبّبه أو من مدى مقاومته للّقاحات أو الأدوية أو أدوات التشخيص أو غيرها من التدابير الاجتماعية والصحّية العامّة. وبسبب ظهور متحوّرات في نهاية 2020 شكّلت خطراً متزايداً على الصحّة العامّة عمدت منظمة الصحة العالمية إلى وضع قائمة بالمتحوّرات التي يجب مراقبتها وتلك المثيرة للقلق، وذلك بهدف أجل إعطاء الأولوية لأنشطة المراقبة والبحث على المستوى العالمي.
وقرّرت منظمة الصحّة العالمية أن تطلق على المتحوّرات التي يجب مراقبتها وتلك المثيرة للقلق أسماء أحرف الأبجدية اليونانية بدلاً من اسم البلد الذي رصدت فيه للمرة الأولى، وذلك منعاً لإلحاق أيّ وصمة بهذا البلد ولتسهيل نطق الأسماء على عامة الناس.
4 نسخ
وفي الوقت الراهن هناك، وفقاً لمنظمة الصحة العالمية، أربع نسخ متحوّرة مثيرة للقلق، بينها المتحورة ألفا التي انتشرت حتى اليوم في 193 دولة والمتحوّرة دلتا التي انتشرت حتى اليوم في 170 دولة، في حين هناك خمس متحوّرات أخرى يجب مراقبتها (بما في ذلك المتحورة "مو").
ورصدت المتحوّرة "مو" للمرة الأولى في كولومبيا في جانفي. ومنذ ذلك الحين تم الإبلاغ عن إصابات بها في عدد من دول أميركا اللاتينية وأوروبا.
وأوضحت منظمة الصحة العالمية أنّه "على الرّغم من أنّ الانتشار العالمي للمتحوّرة مو بين الحالات المتسلسلة قد انخفض ويقلّ حالياً عن 0.1%، إلا أن انتشارها في كولومبيا (39%) والإكوادور (13%) يزيد باضطراد".
وكالات
الرجوع 


















